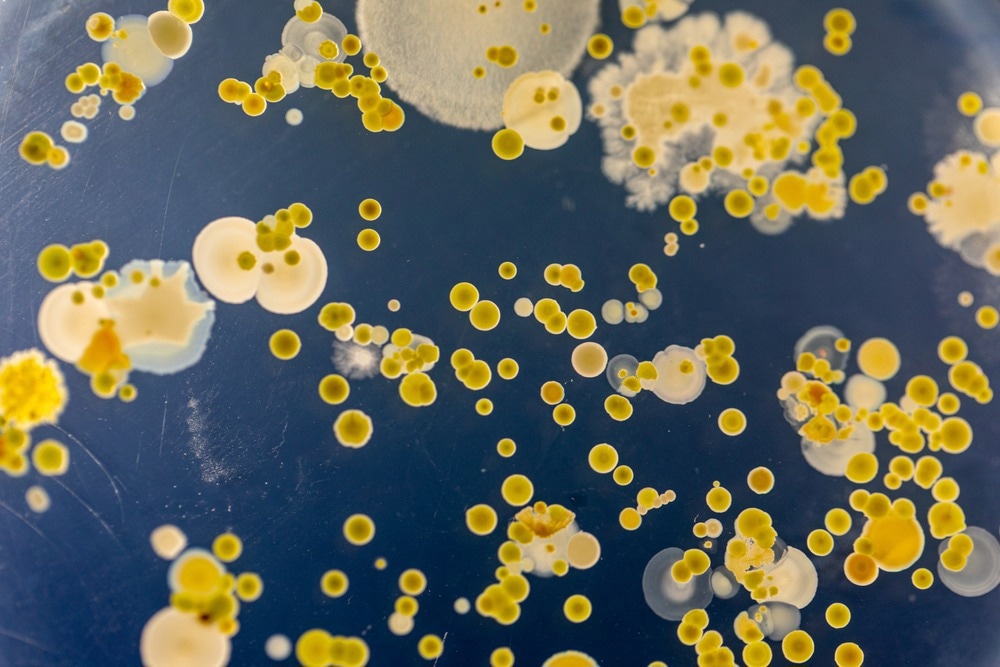

Making sense of the complex metabolic activity of microbial communities is no mean feat. Understanding the stoichiometry and reaction kinetics of this activity typically requires precise quantification of reactants, metabolic products, and the composition of the microbial community itself. Researchers at the universities of Delft and Wageningen in the Netherlands used mass spectrometry, gas chromatography and fluorometry systems from Thermo Scientific to do just this; helping them to gain insight into the effects of pH and product inhibition on chain-elongating microorganisms in sequencing batch bioreactors.1
Image Credit: RattiyaThingdumhyu
Sequencing batch reactors
Sequencing batch reactors are one of the simplest types of bioreactors, each consisting of a single tank in which a full cycle of anaerobic processing is carried out by a community of microorganisms. This cycle consists of four sequential steps (hence “sequencing” bioreactor): feeding, reacting, settling, and decanting.2 Sequencing batch reactors are predominantly used to process wastewater from both municipal and industrial sources. In this capacity, sequencing batch reactors are a relatively new technology – however, their simple configuration and high efficiency in removing suspended solids and reducing biological oxygen demand (BOD) makes them a promising low-cost approach to the effective treatment of dangerous wastewater.
Processing wastewater using sequencing batch reactors has benefits beyond removing contaminants from wastewater and making it safe to return to the water cycle. By harnessing the metabolic power of microorganisms in sequencing batch reactors, researchers are hopeful that it may be possible to convert complex industrial and agricultural waste effluent into recoverable microbial “products”. In the transition away from a petroleum-based society, the microbial production of useful chemicals from renewable resources in this way has gained significant interest.3,4
Such techniques would have potentially enormous ecological and economic benefits. However, the influence of environmental conditions on the stoichiometry and kinetics of many types of reaction that occur in sequencing batch bioreactors remain elusive.
Investigating microbial carboxylic acid chain-lengthening reactions
A team of researchers from the universities of Delft and Wageningen in the Netherlands set out to investigate the effects of environmental factors on a specific type of reaction in a sequencing batch bioreactor: the elongation of short-chain fatty acids through reversed β-oxidation. Processed by microorganisms (in particular Clostridium kluyveri related species), the carbon “backbones” of short chain fatty acids such as butanoic acid, present in complex wastewater streams, are elongated. Product of this metabolic processing is medium-chain carboxylic acids such as hexanoic acid and octanoic acid (also known as caproic acid and caprylic acid, respectively).
Many medium-chain carboxylic acids are valuable compounds. Hexanoic acid, for example, can be used as an antimicrobial agent, as a corrosion inhibitor, and as a precursor for a number of flavors, fragrances, solvents and fuels.5
By tuning the conditions within a reactor, the composition and behavior of microbial communities can be changed in order to suppress or enhance certain reaction types. The team of researchers aimed to explore the influence of environmental factors (in particular, pH and product inhibition) on carboxylic acid chain-lengthening reactions within a sequencing batch reactor in order to help uncover the fundamental aspects of these reactions.
A window into the microbial realm
Sequencing batch bioreactors typically play host to a dynamic community of competing (and cooperating) microbial species. Untangling the complex metabolic processes within a bioreactor and quantifying a particular class of reactions can be challenging.
At the least, it’s generally necessary to keep a detailed inventory of the reactor’s inputs and outputs, and to monitor the presence of specific reactants and products in solution within the reactor. In addition, characterizing the microbial population itself can provide valuable insight into the roles of various microbial species.
Rather than processing real waste streams, the team of researchers created an experimental setup whereby process parameters and microbial conversions could be closely monitored within two 1L batch reactors, each operating for 48 days.
A Thermo Scientific PRIMA BT benchtop mass spectrometer was used to carry out in- and off-gas analysis of the reactors. Designed for process development laboratories, the PRIMA BT uses scanning magnetic-sector technology to deliver accurate, precise and stable on-line gas analysis. Physicochemical modeling enabled off-gas measurements to be converted into bioreactor-specific respiration rates of H2, N2, CO2, and CH4.
Concentrations of butanoic acid (a short chain fatty acid), hexanoic acid (a medium chain carboxylic acid) and ethanol (an electron donor for chain-lengthening reactions) were all measured using a Thermo Scientific Trace 1300 gas chromatograph equipped with an injector maintained at 180 °C. The trace 1300 series is a compact GC system designed to deliver extremely fast results at a low cost of ownership. The unique modular design enables researchers to build only the configuration they need, minimizing costs compared to traditional GC systems.
The team processed samples from the bioreactor into microbial pellets in order to carry out genomic analysis. Prior to DNA sequencing, a Thermo Scientific Qubit 4 fluorometer was used to provide rapid quantification of DNA within the pellets, ensuring that sufficient DNA was present before sending samples off for amplicon sequencing. Providing results in under 3 seconds and requiring as little as 1 µL of sample, the Qubit 4 is unparalleled for simple and rapid DNA/RNA quantification.
Through careful control of process parameters and precise monitoring of reactants, products and microbial populations; the researchers were able to elucidate the effects of varying pH and product inhibition on chain-lengthening reactions within the bioreactors. Their results provided insight into the ways microorganisms deal with energy losses associated with product inhibition, showing that the chain-elongating reactions rely on a balance between substrate uptake and product inhibition.
Thermo Scientific develops world-leading analytical solutions which enable researchers to solve complex challenges in biotechnology. To find out more about the Thermo Scientific systems used in this research – or any of our other analytical systems – get in touch with Thermo Scientific today.
References and Further Reading
- Allaart, M. T., Stouten, G. R., Sousa, D. Z. & Kleerebezem, R. Product Inhibition and pH Affect Stoichiometry and Kinetics of Chain Elongating Microbial Communities in Sequencing Batch Bioreactors. Front. Bioeng. Biotechnol. 9, 693030 (2021).
- Anderson, K., Sallis, P. & Uyanik, S. Anaerobic treatment processes. in Handbook of Water and Wastewater Microbiology 391–426 (Elsevier, 2003). doi:10.1016/B978-012470100-7/50025-X.
- Guerra-Rodríguez, S., Oulego, P., Rodríguez, E., Singh, D. N. & Rodríguez-Chueca, J. Towards the Implementation of Circular Economy in the Wastewater Sector: Challenges and Opportunities. (2020).
- Gherghel, A., Teodosiu, C. & De Gisi, S. A review on wastewater sludge valorisation and its challenges in the context of circular economy. Journal of Cleaner Production 228, pp. 244–263 (2019).
- Biological formation of caproate and caprylate from acetate: fuel and chemical production from low grade biomass - Energy & Environmental Science (RSC Publishing). https://pubs.rsc.org/en/content/articlelanding/2011/ee/c0ee00282h.
About Thermo Fisher Scientific – Environmental and Process Monitoring Instruments
We design and manufacture industry-leading products for Gas & particulate pollutants, Flow, gas and liquid measurement, Process analytical measurements, and Industrial Hygiene.
Technologies have proven to help customers improve efficiency, ensure process and quality control, maintain regulatory compliance, and increase worker safety.
Process mass spectrometers
Maximize product yield and increase profitability with process mass spectrometry analysis. Process gas analyzers are engineered to meet a number of challenging process applications in the petrochemical, iron, and steel, and biotechnology industries. Highly reliable and easy-to-own, Thermo Fisher Scientific process gas analysis technologies deliver faster, more complete, lab-quality online gas analysis and process analytics. Learn More
Process analytical technology/Biopharma
Process Analytical Technology (PAT) is a regulatory framework initiated by the United States’ Food and Drug Administration (FDA) that encourages pharmaceutical manufacturers to improve the process of pharmaceutical development, manufacturing, and quality control.
PAT aims to improve process efficiency by defining Critical Process Parameters (CPP) and monitoring these CPPs to stay within a defined limit, either in-line or on-line to maintain a product’s Critical Quality Attributes (CQA). Monitoring CPPs with process mass spectrometry gas analysis reduces over-processing, pinpoints contaminants, and increase product consistency. Learn More
Industrial hygiene
Industrial hygiene instruments keep your investments secure, your facilities compliant with local regulations, and your workers safe from leaking pollutants, gases, or toxic vapors. Make sure you have the most updated technology, with access to repair and calibration support to maintain reliable gas monitoring. With our environmental expertise, you can breathe easy knowing your company, workers, and neighboring communities have cleaner, safer, and healthier air quality. Learn More
Sulfur analyzers
Online sulfur analyzers replace expensive and time-consuming laboratory sampling. Get fast responses and wide measurement ranges of trace sulfur and total sulfur in flare gas, liquid, and vapor for reliable emissions monitoring. Learn More
Gas & particulate analyzers
Increasingly stringent regulatory requirements are making it more difficult to maintain regulatory compliance and optimal process performance. Air quality monitoring and reporting requirements in the U.S., China, India, Europe, and Latin America are shifting and being redefined. Together we can arrive at solutions that make sound business sense. Learn More
Flow measurement
Flow measurement and process control are critical aspects of producing, handling, and transporting hydrocarbons around the world. With our Thermo Scientific suite of flow computers and flow meters, we enable our customers to reduce cost, decrease lost material, automate, and monitor critical points in processes. From field to control room and upstream to downstream, our products provide greater control, confidence, and reliability. Learn More
Sponsored Content Policy: News-Medical.net publishes articles and related content that may be derived from sources where we have existing commercial relationships, provided such content adds value to the core editorial ethos of News-Medical.Net which is to educate and inform site visitors interested in medical research, science, medical devices and treatments.